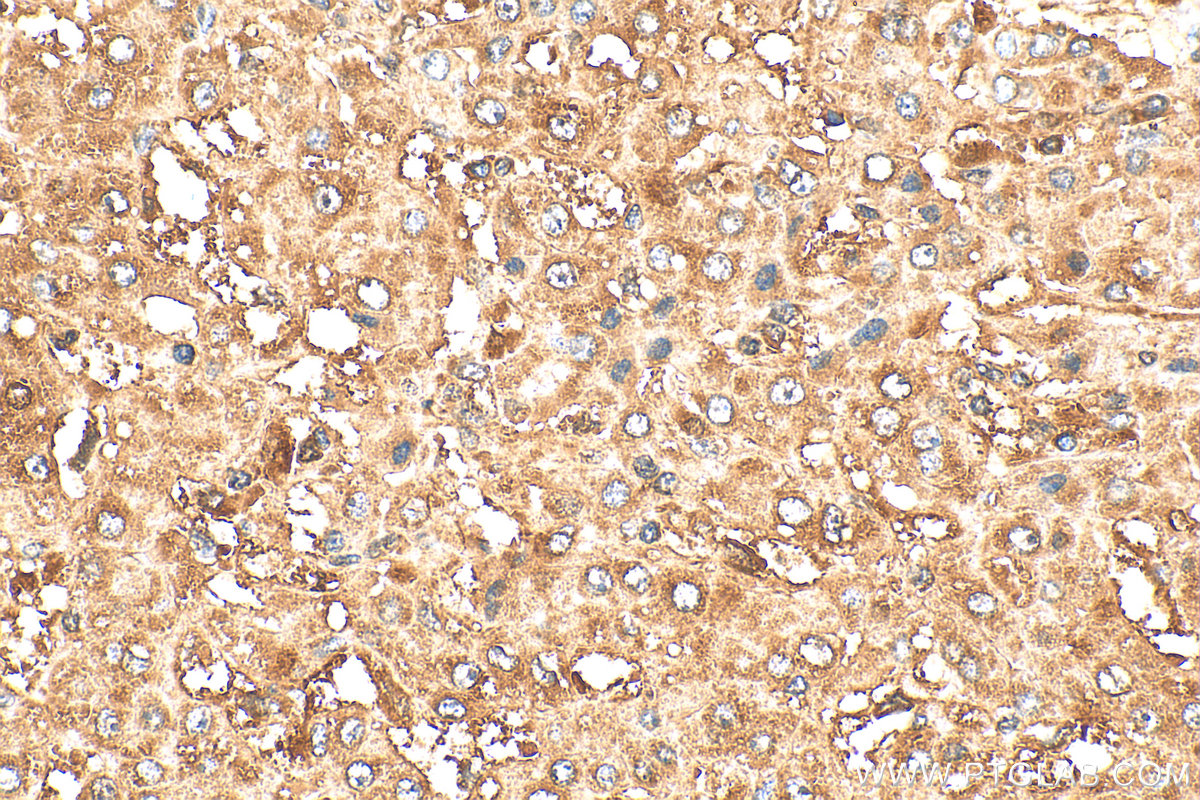
Immunohistochemistry (IHC) staining of human liver cancer tissue using HPRT Polyclonal antibody (15059-1-AP)

Tested Applications
| Positive WB detected in | HeLa cells, HEK-293 cells, A549 cells, mouse liver tissue, MCF-7 cells, HepG2 cells, Jurkat cells, Y79 cells, NIH/3T3 cells, mouse brain tissue, rat brain tissue |
| Positive IP detected in | mouse brain tissue |
| Positive IHC detected in | mouse brain tissue, human liver cancer tissue, human pancreas tissue Note: suggested antigen retrieval with TE buffer pH 9.0; (*) Alternatively, antigen retrieval may be performed with citrate buffer pH 6.0 |
| Positive IF/ICC detected in | HeLa cells |
| Positive FC (Intra) detected in | HeLa cells |
Recommended dilution
| Application | Dilution |
|---|---|
| Western Blot (WB) | WB : 1:2000-1:10000 |
| Immunoprecipitation (IP) | IP : 0.5-4.0 ug for 1.0-3.0 mg of total protein lysate |
| Immunohistochemistry (IHC) | IHC : 1:200-1:800 |
| Immunofluorescence (IF)/ICC | IF/ICC : 1:200-1:800 |
| Flow Cytometry (FC) (INTRA) | FC (INTRA) : 0.40 ug per 10^6 cells in a 100 µl suspension |
| It is recommended that this reagent should be titrated in each testing system to obtain optimal results. | |
| Sample-dependent, Check data in validation data gallery. | |
Published Applications
| KD/KO | See 4 publications below |
| WB | See 32 publications below |
| IHC | See 2 publications below |
| IF | See 2 publications below |
Product Information
15059-1-AP targets HPRT in WB, IHC, IF/ICC, FC (Intra), IP, ELISA applications and shows reactivity with human, mouse, rat samples.
| Tested Reactivity | human, mouse, rat |
| Cited Reactivity | human, mouse, rat |
| Host / Isotype | Rabbit / IgG |
| Class | Polyclonal |
| Type | Antibody |
| Immunogen |
CatNo: Ag7044 Product name: Recombinant human HPRT1 protein Source: e coli.-derived, PET28a Tag: 6*His Domain: 1-218 aa of BC000578 Sequence: MATRSPGVVISDDEPGYDLDLFCIPNHYAEDLERVFIPHGLIMDRTERLARDVMKEMGGHHIVALCVLKGGYKFFADLLDYIKALNRNSDRSIPMTVDFIRLKSYCNDQSTGDIKVIGGDDLSTLTGKNVLIVEDIIDTGKTMQTLLSLVRQYNPKMVKVASLLVKRTPRSVGYKPDFVGFEIPDKFVVGYALDYNEYFRDLNHVCVISETGKAKYKA Predict reactive species |
| Full Name | hypoxanthine phosphoribosyltransferase 1 |
| Calculated Molecular Weight | 25 kDa |
| Observed Molecular Weight | 24-28 kDa |
| GenBank Accession Number | BC000578 |
| Gene Symbol | HPRT1 |
| Gene ID (NCBI) | 3251 |
| RRID | AB_10638622 |
| Conjugate | Unconjugated |
| Form | Liquid |
| Purification Method | Antigen affinity purification |
| UNIPROT ID | P00492 |
| Storage Buffer | PBS with 0.02% sodium azide and 50% glycerol, pH 7.3. |
| Storage Conditions | Store at -20°C. Stable for one year after shipment. Aliquoting is unnecessary for -20oC storage. 20ul sizes contain 0.1% BSA. |
Background Information
HPRT, also named HPRT1 and HGPRT, plays a central role in the generation of purine nucleotides through the purine salvage pathway. Mutation of HPRT1 is associated with Lesch-Nyhan syndrome (LNS) which is an X-linked inherited neurogenetic disorder of purine metabolism. It has been reported that HPRT1 also plays an important role in HPRT-related gout.
Protocols
| Product Specific Protocols | |
|---|---|
| FC protocol for HPRT antibody 15059-1-AP | Download protocol |
| IF protocol for HPRT antibody 15059-1-AP | Download protocol |
| IHC protocol for HPRT antibody 15059-1-AP | Download protocol |
| IP protocol for HPRT antibody 15059-1-AP | Download protocol |
| WB protocol for HPRT antibody 15059-1-AP | Download protocol |
| Standard Protocols | |
|---|---|
| Click here to view our Standard Protocols |
Publications
| Species | Application | Title |
|---|---|---|
J Clin Invest Sirtuin 2 regulates cellular iron homeostasis via deacetylation of transcription factor NRF2. | ||
J Clin Invest ZFP36L2 suppresses mTORc1 through a P53-dependent pathway to prevent peri-partum cardiomyopathy in mice. | ||
Cell Rep Mitochondrial dynamics define muscle fiber type by modulating cellular metabolic pathways | ||
Br J Cancer Blocking of oestrogen signals improves anti-tumour effect regardless of oestrogen receptor alpha expression in cancer cells | ||
EMBO Rep MYC promotes cancer progression by modulating m6 A modifications to suppress target gene translation. | ||
Elife Aging is associated with increased brain iron through cortex-derived hepcidin expression. |